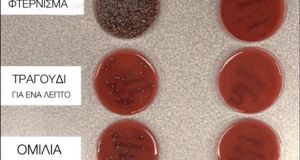

Η Ευρωπαϊκή Επιτροπή επενδύει 1 δισ. ευρώ σε καινοτόμα έργα καθαρών τεχνολογιών. Σήμερα η Επιτροπή εγκαινιάζει την πρώτη πρόσκληση υποβολής προτάσεων στο πλαίσιο του Ταμείου Καινοτομίας,...


Πρωταθλητές Ευρώπης στις προηγμένες ψηφιακές δεξιότητες – advanced digital skills – που αποτελούν ένα ασφαλές διαβατήριο για τη σύγχρονη αγορά εργασίας, αναδεικνύονται οι Φινλανδοί. Τους “συνήθεις...


Στην Ινδία η κυβέρνηση αποκλείει το Tik Tok και 58 άλλες κινεζικές εφαρμογές μετά τις συνεχιζόμενες εντάσεις στα σύνορα Ινδίας – Κίνας. Τις τελευταίες εβδομάδες, οι σχέσεις ανάμεσα...


Επιτυχίες εκτός ελληνικών συνόρων γνωρίζει ήδη, στις πρώτες δοκιμασίες μετά τη σύστασή της, η ομάδα ΒEAM (Beyond Earth Aristotle Missions) του ΑΠΘ, η οποία ασχολείται με...


Ένα μοναδικό άστρο αποτύπωσε το θρυλικό διαστημικό τηλεσκόπιο Hubble. Πρόκειται για ένα άστρο που περιτριγυρίζεται από ένα δίσκο σκόνης και αερίων δημιουργώντας έτσι την εικόνα ότι το...


Οι απατεώνες ανακαλύπτουν συνεχώς νέους τρόπους για να αποσπούν χρήματα από ανυποψίαστα θύματα μέσω Facebook. Δείτε τι πρέπει να προσέχετε. Πολλές είναι οι απάτες που κυκλοφορούν...


Σε αύξηση της συνολικής ισχύος που μπορεί να δημοπρατηθεί μέσω ανταγωνιστικών διαδικασιών φέτος προσανατολίζεται το ΥΠ.ΕΝ., καθώς το 75% δημοπρατείται έως τον Ιούλιο. Τον σχεδιασμό της...


Σε έναν αγώνα δρόμου, προκειμένου να τιθασεύσουν τις δαπάνες τους, έχουν επιδοθεί οι επιχειρήσεις ανά τον κόσμο, σε μια προσπάθεια να διαχειριστούν τον αντίκτυπο της πανδημίας...


Για τον κορωνοϊό μίλησε σε τηλεοπτική του συνέντευξη το πρωί της Τετάρτης (1/7) ο καθηγητής Λοιμωξιολογίας Νικόλαος Σύψας επισημαίνοντας πως ήδη προετοιμαζόμαστε για το 2ο κύμα...


Τι πρέπει να κάνουμε στα κλιματιστικά των σπιτιών μας και των αυτοκινήτων, προκειμένου να λειτουργούν σωστά και να μην υπάρχει κίνδυνος εν μέσω κορωνοϊού. Tις απόψεις...

Η φωτογραφία που αποδεικνύει τη σημασία των μέτρων προστασίας από τον κορωνοϊό Ο καθηγητής του LSE, Ηλίας Μόσιαλος, δημοσίευσε στο facebook μία φωτογραφία ο οποία δείχνει...


Θεσπίζεται περιβαλλοντική εισφορά από το 2022 για τα πλαστικά που θα μείνουν στην αγορά – Έρχονται μεγάλες καμπάνες για τους παραβάτες – Τι προβλέπει το νομοσχέδιο...


Στα 6,2 δις. ευρώ (έναντι 3,7-4,4 δις. ευρώ προηγουμένως) εκτιμάται ότι μπορούν να ανέλθουν οι ευρωπαϊκοί και εθνικοί πόροι για την απολιγνιτοποίηση στην Ελλάδα με βάση...


Η Rakuten Viber, η εταιρεία πίσω από την κορυφαία εφαρμογή επικοινωνίας αποφάσισε να διακόψει κάθε επιχειρηματική σχέση με το Facebook. Η εφαρμογή θα αφαιρέσει τα Facebook...